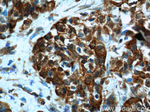
Cadherin-17 Antibody in Immunohistochemistry (Paraffin) (IHC (P))

Search
Proteintech
Cadherin-17 Polyclonal Antibody
{{$productOrderCtrl.translations['antibody.pdp.commerceCard.promotion.promotions']}}
{{$productOrderCtrl.translations['antibody.pdp.commerceCard.promotion.viewpromo']}}
{{$productOrderCtrl.translations['antibody.pdp.commerceCard.promotion.promocode']}}: {{promo.promoCode}} {{promo.promoTitle}} {{promo.promoDescription}}. {{$productOrderCtrl.translations['antibody.pdp.commerceCard.promotion.learnmore']}}
产品信息
24339-1-AP
种属反应
已发表种属
宿主/亚型
分类
类型
抗原
偶联物
形式
浓度
规格
纯化类型
保存液
内含物
保存条件
运输条件
产品详细信息
Immunogen sequence: RSTHNLQVA ALDANGIIVE GPVPITIEVK DINDNRPTFL QSKYEGSVRQ NSRPGKPFLY VNATDLDDPA TPNGQLYYQI VIQLPMINNV MYFQINNKTG AISLTREGSQ ELNPAKNPSY NLVISVKDMG GQSENSFSDT TSVDIIVTEN IWKAPKPVEM VENSTDPHPI KITQVRWNDP GAQYSLVDKE KLPRFPFSID QEGDIYVTQP LDREEKDAYV FYAVAKDEYG KPLSYPLEIH VKVKDINDNP PTCPSPVTVF EVQENERLGN SIGTLTAHDR DEENTANSFL NYRIVEQTPK LPMDGLFLIQ TYAGMLQLA (89-406 aa encoded by BC113464)
靶标信息
CDH17 gene is a member of the cadherin superfamily, genes encoding calcium-dependent, membrane-associated glycoproteins. The encoded protein is cadherin-like, consisting of an extracellular region, containing 7 cadherin domains, and a transmembrane region but lacking the conserved cytoplasmic domain. The protein is a component of the gastrointestinal tract and pancreatic ducts, acting as an intestinal proton-dependent peptide transporter in the first step in oral absorption of many medically important peptide-based drugs. The protein may also play a role in the morphological organization of liver and intestine. Alternative splicing results in multiple transcript variants.
仅用于科研。不用于诊断过程。未经明确授权不得转售。
生物信息学
蛋白别名: BILL-cadherin; Cadherin; cadherin 17, LI cadherin (liver-intestine); cadherin-16; Cadherin-17; FLJ26931; HPT-1 cadherin; human intestinal peptide-associated transporter HPT-1; human peptide transporter 1; Intestinal peptide-associated transporter HPT-1; LI cadherin; LI-cadherin; Liver-intestine cadherin; MGC138218; MGC142024; P130; unnamed protein product
基因别名: CDH16; CDH17; HPT-1; HPT-1/LI; HPT1
UniProt ID: (Human) Q12864, (Mouse) Q9R100
Entrez Gene ID: (Human) 1015, (Mouse) 12557